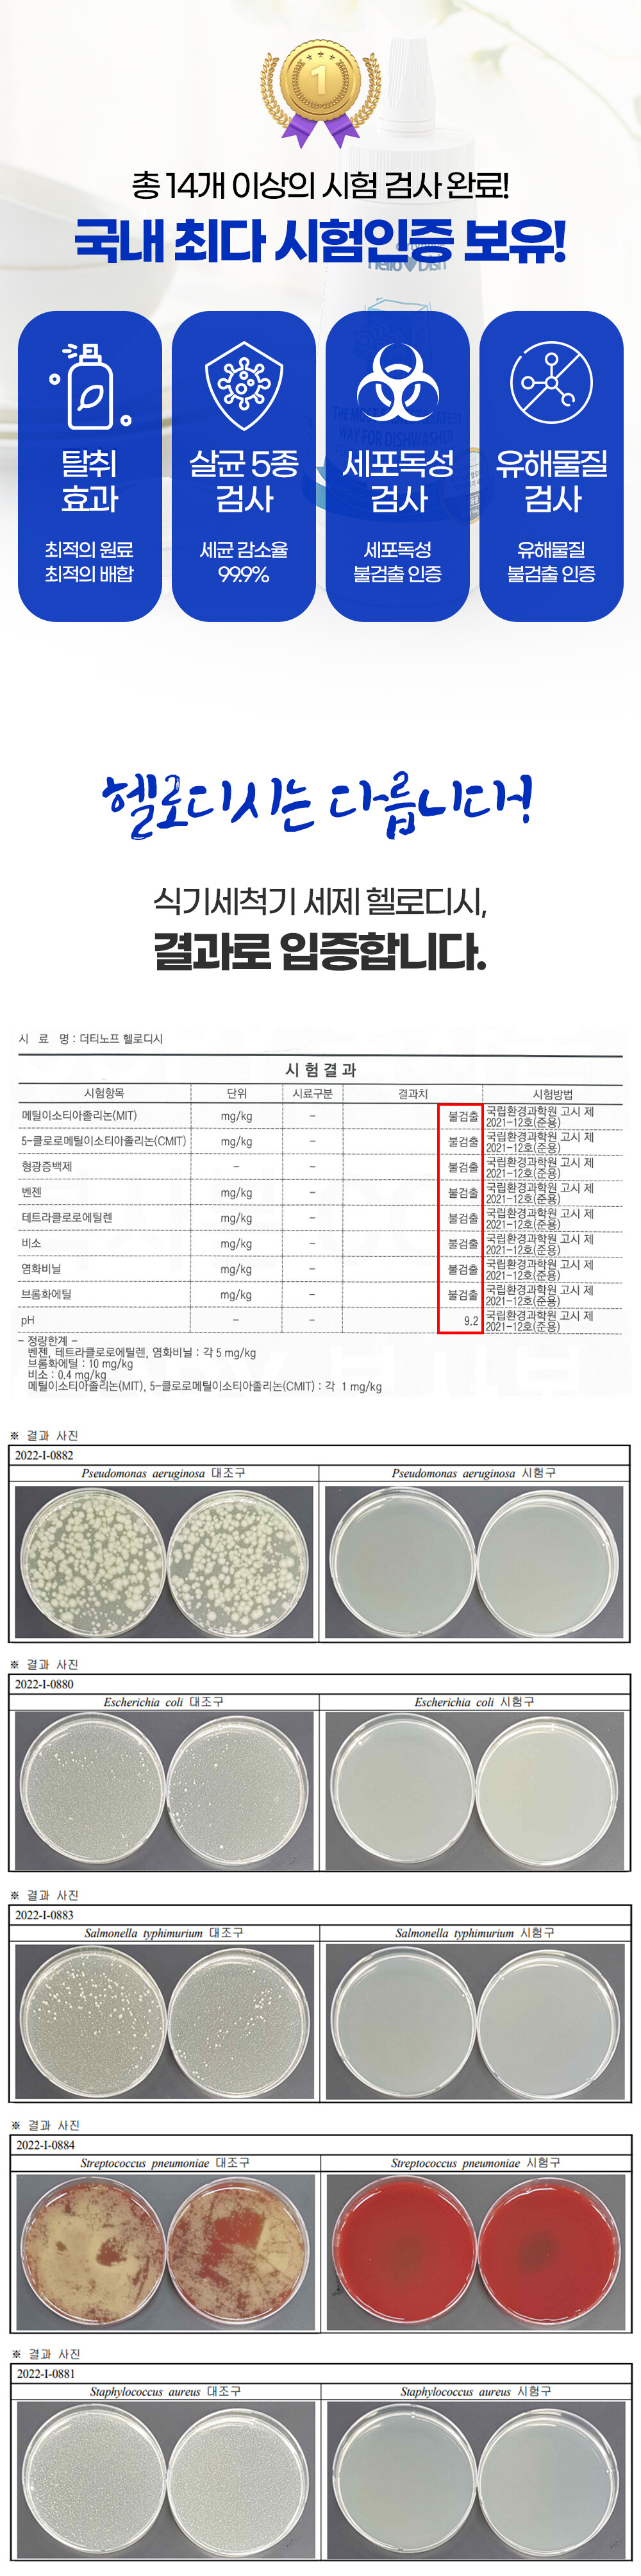

헬로디시 식기세척기 세제(400g/1kg)
* 본품
- 편리하고 위생적인 분말 용기 타입
- 전 성분 1종 원료를 사용한 세척제
- 스푼 NO! 손쉬운 세제 투입
- 2종 성분 NO! 잔여물 걱정 제로
- 별도의 린스 사용 NO! 올인원 세제
* 리필
- 가성비 대용량 지퍼백 타입
- 전 성분 1종 원료를 사용한 세척제
- 스푼 NO! 손쉬운 세제 투입
- 2종 성분 NO! 잔여물 걱정 제로
- 별도의 린스 사용 NO! 올인원 세제
- 편리하고 위생적인 분말 용기 타입
- 전 성분 1종 원료를 사용한 세척제
- 스푼 NO! 손쉬운 세제 투입
- 2종 성분 NO! 잔여물 걱정 제로
- 별도의 린스 사용 NO! 올인원 세제
* 리필
- 가성비 대용량 지퍼백 타입
- 전 성분 1종 원료를 사용한 세척제
- 스푼 NO! 손쉬운 세제 투입
- 2종 성분 NO! 잔여물 걱정 제로
- 별도의 린스 사용 NO! 올인원 세제
15,900원
19,800원
배송비
-
세트구성
선택하세요.
선택하세요.
본품400g
본품400g+리필1kg
(+19,000원)
주문 수량
0개
총 상품 금액
0원
헬로디시 식기세척기 세제(400g/1kg)
15,900원
19,800원
세트구성
선택하세요.
선택하세요.
본품400g
본품400g+리필1kg
(+19,000원)
주문 수량
0개
총 상품 금액
0원